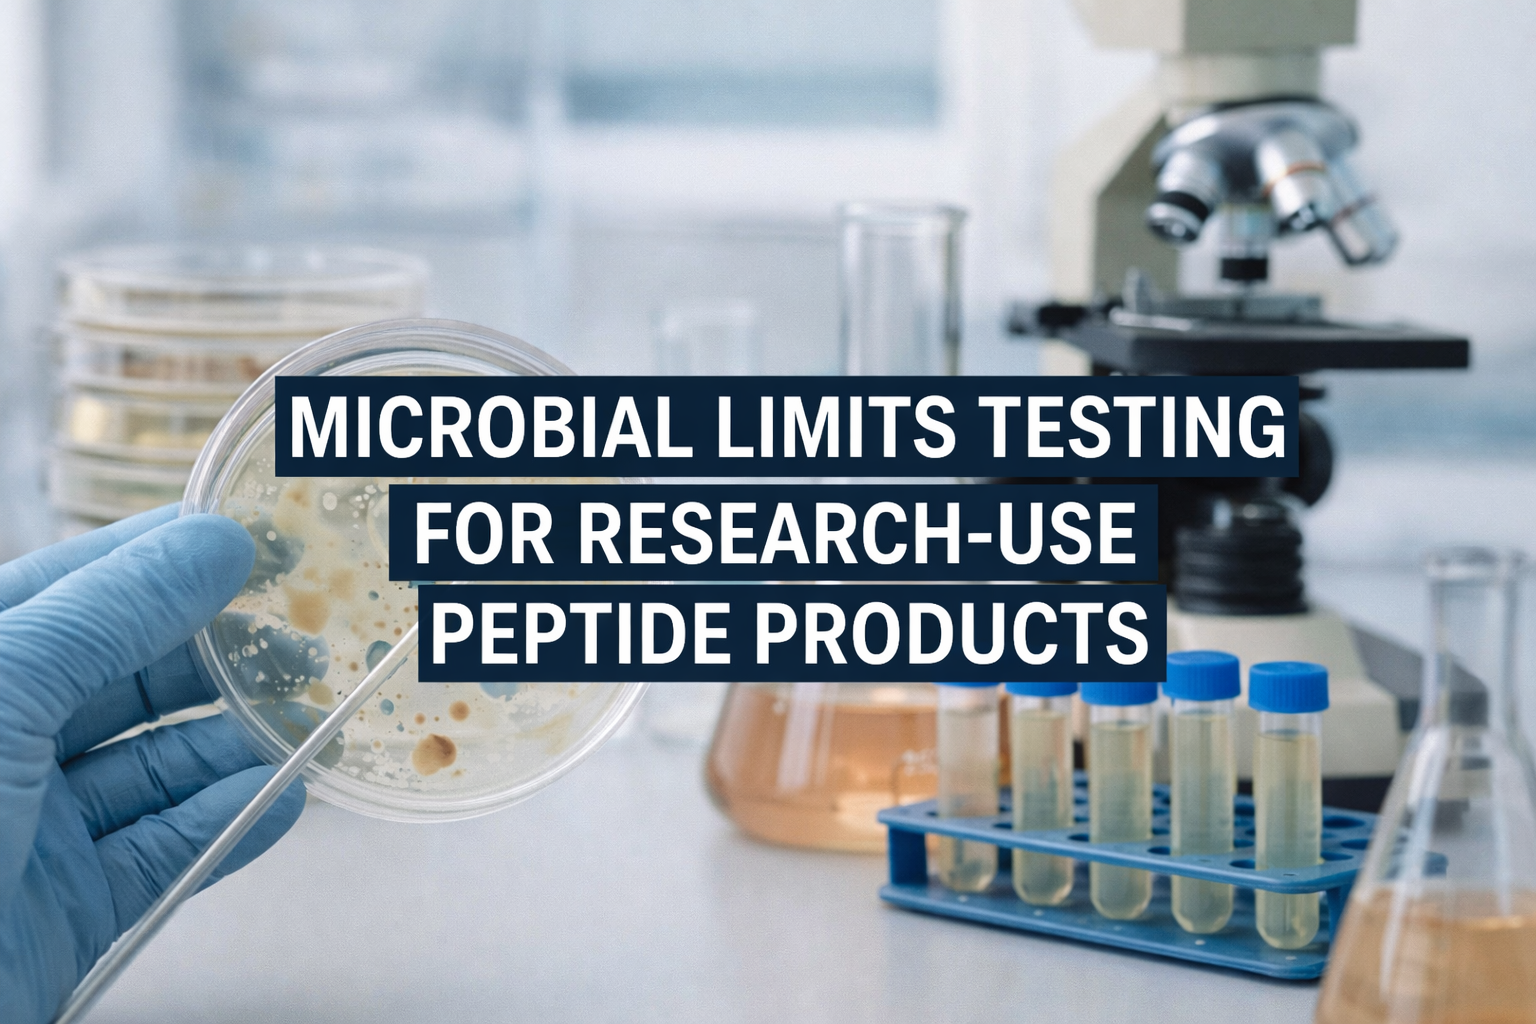
Microbial Limits Testing for Research Use peptides

Blend: Ipamorelin CJC129 No DAC
Peptide Information and Research Hub
Welcome to the Peptide Information and Research Hub — your central source for credible, science-based insights into peptide science, formulation, and laboratory research. Here, we explore the chemistry, stability, and analytical testing of peptides through verified data and peer-reviewed studies. Whether you’re a researcher, student, or industry professional, this hub provides detailed articles, visuals, and references to help you understand every aspect of peptide development — from synthesis and purification to stability testing and quality assurance.